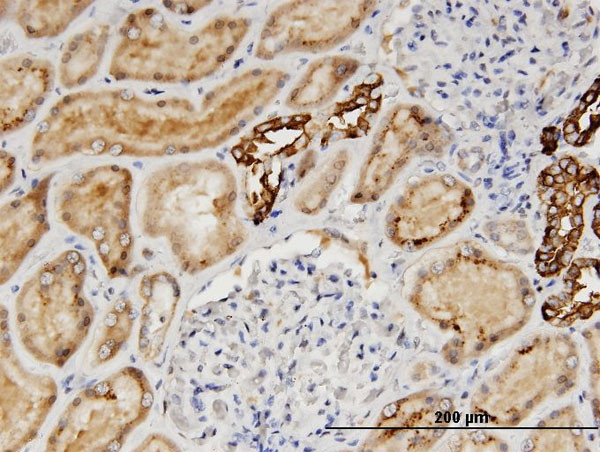
AGT Antibody in Immunohistochemistry (Paraffin) (IHC (P))

Search
Abnova
AGT Monoclonal Antibody (3C10)
{{$productOrderCtrl.translations['antibody.pdp.commerceCard.promotion.promotions']}}
{{$productOrderCtrl.translations['antibody.pdp.commerceCard.promotion.viewpromo']}}
{{$productOrderCtrl.translations['antibody.pdp.commerceCard.promotion.promocode']}}: {{promo.promoCode}} {{promo.promoTitle}} {{promo.promoDescription}}. {{$productOrderCtrl.translations['antibody.pdp.commerceCard.promotion.learnmore']}}


Please note: We are reviewing Western blot images included in the antibody testing data in our catalog, including those provided by third parties. Unless expressly labeled or annotated as “raw-unedited”, Western blot images included in the antibody testing data in our catalog may have been edited, optimized or otherwise adjusted for presentation.
产品信息
H00000183-M04
种属反应
宿主/亚型
分类
类型
克隆号
抗原
偶联物
形式
浓度
规格
纯化类型
保存液
内含物
保存条件
运输条件
产品详细信息
Sequence of this protein is as follows: MRKRAPQSEM APAGVSLRAT ILCLLAWAGL AAGDRVYIHP FHLVIHNEST CEQLAKANAG KPKDPTFIPA PIQAKTSPVD EKALQDQLVL VAAKLDTEDK LRAAMVGMLA NFLGFRIYGM HSELWGVVHG ATVLSPTAVF GTLASLYLGA LDHTADRLQA ILGVPWKDKN CTSRLDAHKV LSALQAVQGL LVAQGRADSQ AQLLLSTVVG VFTAPGLHLK QPFVQGLALY TPVVLPRSLD FTELDVAAEK IDRFMQAVTG WKTGCSLTGA SVDSTLAFNT YVHFQGKMKG FSLLAEPQEF WVDNSTSVSV PMLSGMGTFQ HWSDIQDNFS VTQVSFTESA CLLLIQPHYA SDLDKVEGLT FQQNSLNWMK KLSPRTIHLT MPQLVLQGSY DLQDLLAQAE LPAILHTELN LQKLSNDRIR VGEVLNSIFF ELEADEREPT ESTQQLNKPE VLEVTLNRPF LFAVYDQSAT ALHFLGRVAN PLSTA
靶标信息
The protein encoded by AGT, pre-angiotensinogen or angiotensinogen precursor, is expressed in the liver and is cleaved by the enzyme renin in response to lowered blood pressure. The resulting product, angiotensin I, is then cleaved by angiotensin converting enzyme (ACE) to generate the physiologically active enzyme angiotensin II. The protein is involved in maintaining blood pressure and in the pathogenesis of essential hypertension and preeclampsia. Mutations in this gene are associated with susceptibility to essential hypertension, and can cause renal tubular dysgenesis, a severe disorder of renal tubular development. Defects in this gene have also been associated with non-familial structural atrial fibrillation, and inflammatory bowel disease.
仅用于科研。不用于诊断过程。未经明确授权不得转售。